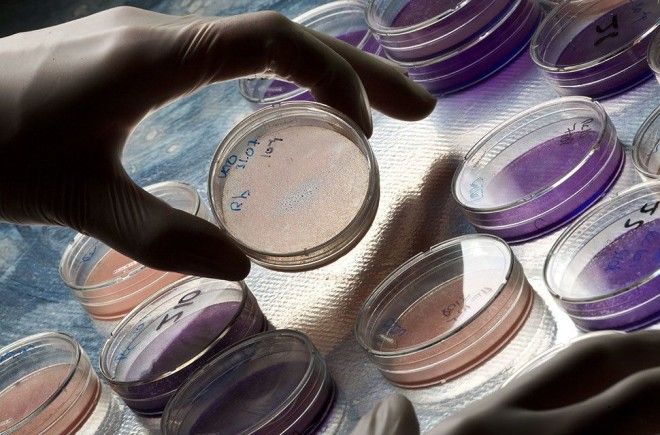

Medicimage/REX/Shutterstock
1. Емкость мозга человека превышает 4 терабайта.

REX/Shutterstock
2. Среднее человеческое тело содержит достаточно серы, чтобы убить всех блох на средней собаке; углерода — чтобы изготовить 900 карандашей; калия — чтобы выстрелить из игрушечной пушки; жира — чтобы сделать 7 кусков мыла; и достаточно воды, чтобы заполнить бочку в 50 литров.

3. Человек по имени Чарльз Осборн икал в течение 68 лет.

Best Shot Factory/REX/Shutterstock
4. Весной частота дыхания в среднем на 1/3 выше, чем осенью.

Jennifer Jacquemart/REX/Shutterstock
5. Чувство жажды появляется при потере воды, равной 1% от веса тела. Потеря более 5% может привести к обмороку, а более 10% — к смерти от иссушения.

Stuart Forster/REX/Shutterstock
6. Всех людей на планете можно с комфортом уложить в куб со стороной 1000 метров.

Photofusion/REX/Shutterstock
7. В мире всего 7% левшей.

Mode/REX/Shutterstock
8. Средний человек за всю свою жизнь проглатывает 8 маленьких пауков.
The Lighthouse / Universal Images Group/REX/Shutterstock
9. Общий вес бактерий, живущих в организме человека, составляет 2 килограмма.

Jeremy Laffon/Solent News/REX/Shutterstock
10. Абсолютная сила жевательных мышц на одной стороне равна 195 килограммам.

Mood Board/REX/Shutterstock
11. Поцелуй достаточной продолжительности гораздо лучше, чем жвачка, нормализует кислотность в полости рта.

West Coast Surfer / Mood Board/REX/Shutterstock
12. За время жизни кожа человека сменяется примерно 1000 раз.

Mint Images/REX/Shutterstock
13. У блондинов борода растет быстрее, чем у брюнетов.

Jaffa Cakes/REX/Shutterstock
14. Самая сильная мышца в человеческом теле — язык.

Sinopix/REX/Shutterstock
15. В возрасте 60 лет большинство людей теряют половину своих вкусовых рецепторов.

HAP/Quirky China News/REX/Shutterstock
16. По статистике, лишь один человек на 2 миллиарда перешагивает порог 116 лет.

DEA PICTURE LIBRARY / UIG/REX/Shutterstock
17. Мышцы фокусировки глаза двигаются 100 000 раз в день. Чтобы мышцы ног сделали столько же сокращений, нужно ходить 80 километров в день.

Ulf Lundin/REX/Shutterstock
18. Невозможно чихнуть с открытыми глазами.

Isopix/REX/Shutterstock
19. Нормальный человек умрет от полного отсутствия сна быстрее, чем от голода. Смерть произойдет примерно через 10 дней без сна, в то время как от голода — через несколько недель.

Mint Images/REX/Shutterstock
20. Средняя продолжительность жизни — 2 475 576 000 секунд, за жизнь мы произносим в среднем 123 205 750 слов, занимаемся сексом 4239 раз.

